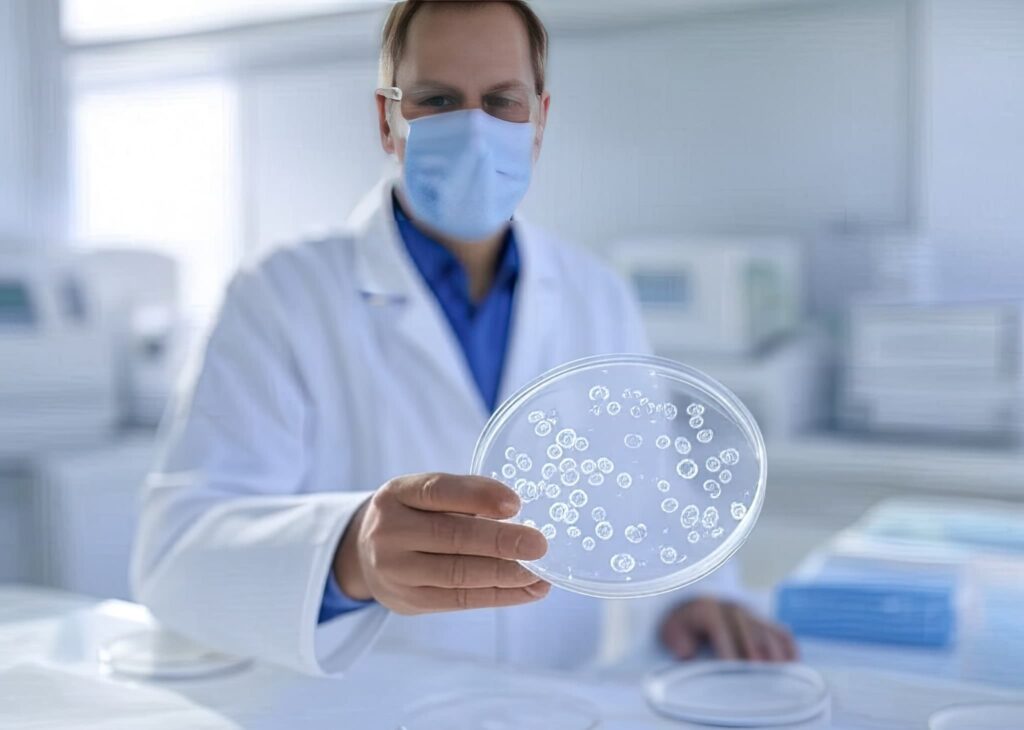

If you have a child or family member with autism, you know what it’s like to face exhausting daily challenges. It’s not just a medical label, but something that transforms family dynamics. A simple talk, which others take for granted, can become a difficult puzzle. Those repetitive behaviors, unique to the disorder, often baffle those who don’t experience it firsthand. Fortunately, science is advancing and bringing options unthinkable years ago. Among them, stem cell treatment is generating a lot of interest. Could it be the key you are looking for? Turkey has positioned itself as a leading country in this therapy. More than a few families are crossing borders with hope. But the question is: Is it solid or just an uncertain hope?
Understanding autism and its challenges
Autism Spectrum Disorder (ASD) does not fit a single description. Each person experiences it differently. Some barely manage to say a few words, while others become obsessed with a subject. The signs appear in childhood, and detecting them early can change everything. Finding an effective treatment is complicated, like looking for a needle in a haystack. Still, advances allow hope to be maintained.
What is stem cell treatment for autism?
Talking about stem cells sounds futuristic, but in medicine they are an important reality. Their ability to regenerate and repair tissues is remarkable. For this reason, they are being studied to treat many diseases. In autism, they could help the brain and the immune system. Both are often maladjusted in people with ASD.
Stem cell mechanism of action
Some studies indicate that autism may be linked to brain inflammation. If this is true, stem cells could stabilize the brain. They also appear to protect neurons and foster new connections. Imagine your child being able to speak more clearly or understand what’s going on better. It doesn’t take a miracle, sometimes a small breakthrough is a big change.
Many parents report that, after therapy, their children are more connected or conversational. But don’t exaggerate: It’s not a miracle cure and research is still limited. But it definitely helps brain regeneration in autism.
Applications in neurological disorders
Autism is not the only focus of study. Stem cells could also treat cerebral palsy, spinal cord injuries and neurodegenerative diseases. The idea of regenerating neurons opens new doors. Early results are promising, but conclusive evidence is still lacking.
For many families, any hope is enough to keep going. Is it a revolution or just another step in research? Only time will tell. If you are considering this option, be well informed, consult experts and don’t make hasty decisions. In health, it is better to proceed with caution.
Efficacy of stem cells in autism treatment
Treatment of autism with stem cells is of interest to the medical community and many families. Although still under investigation, preliminary studies and testimonials indicate that it could be a promising option.
Recent clinical studies
Stem cells improve brain function by reducing inflammation and regulating the immune system. This could reduce symptoms of autism. Although studies are ongoing, early results are generating optimism among specialists and interested families.
Patient and family testimonials
More and more families are choosing this therapy in Turkey, a benchmark in regenerative medicine. One example is Serwan, a four-year-old boy treated in Istanbul. After the therapy, his communication and social skills improved significantly, transforming the family dynamics.
Turkey as a leading medical treatment destination
Turkey is a key destination for advanced medical treatments. Its modern infrastructure and advanced technology position it as a leader. Investment in research has enabled important advances in this field.
Advances in stem cell therapies
In Turkey, specialized clinics have designed innovative protocols for treating autism with stem cells. These practices have scientific backing and are carried out by highly qualified professionals. This gives confidence to interested families.
Benefits of choosing Turkey for specialized treatments
Choosing treatment in Turkey provides access to innovative therapies and other key benefits.
Affordable costs
Competitive prices without compromising quality of service.
Advanced infrastructure
Hospitals with state-of-the-art technology guarantee effective diagnosis and treatment.
Trained professionals
Internationally recognized specialists ensure first class care.
VisitandMedCare: Your partner in innovative treatments
For those looking for a stem cell clinic in Istanbul, VisitandMedCare is a leader in health tourism. Based in Turkey, it facilitates access to advanced medical therapies.
Customized services for international patients
VisitandMedCare organizes the entire process, from the choice of treatment to the logistics of the trip. It takes care of medical advice, coordination with hospitals and continuous accompaniment.
State-of-the-art facilities and specialized professionals
The company collaborates with prestigious clinics and highly qualified professionals. It ensures that patients receive care in modern and well-equipped facilities.
Testimonials from satisfied patients
VisitandMedCare shares patient testimonials on social networks such as Instagram. These stories show real experiences of families and their results. Although you can also check out our reviews on Google.
Although stem cell research for autism in Turkey is still ongoing, progress is encouraging. Each family must consider their options and make informed decisions. Reliable allies are key.
Important considerations before treatment
If you want to submit your child to cell therapy for autism, you should consider several aspects before deciding. It is key to be well informed.

Personalized medical evaluation
Every patient is different. That is why a detailed medical evaluation by specialists is essential. It will allow to know if the treatment is adequate.
This analysis will also help you understand the possible outcomes in your case. You will then be able to make a decision with realistic expectations.
Potential risks and expectation management
Cell therapy for autism has shown promising advances. However, results may vary depending on the individual patient and his or her situation.
Studies are still underway to determine its long-term efficacy. Therefore, it is important to analyze benefits and limitations carefully.
Procedure for accessing treatment with VisitandMedCare
VisitandMedCare facilitates access to innovative treatments in Turkey. Its process is designed to help international patients.
Initial consultation and trip planning
It all starts with a personalized medical consultation. Your case will be evaluated and the best possible treatment plan will be defined.
Once the procedure is confirmed, you will receive assistance in organizing the trip. Lodging, transportation and other necessary details will be coordinated.
Treatment process and postoperative follow-up
During the treatment, specialized physicians will administer stem cells according to established protocols. A safe and effective process will be guaranteed at all times. Depending on your situation, the application will be intravenous or by localized injections. The best option for your case will be chosen.
Subsequent follow-up is essential. Controls will be carried out to evaluate your evolution, measure progress and offer additional recommendations. This accompaniment optimizes the results and guarantees a good recovery. In the end, your well-being is the most important thing.
Frequently asked questions about stem cell therapy for autism
In recent years, stem cell therapy for autism in Turkey has captured the attention of many families. It is normal to look for options to improve the life of a loved one with autism. This treatment arouses hope, but also uncertainty. Below we resolve frequent doubts in a clear and straightforward manner.
1. Can stem cell therapy cure autism?
There is no definitive cure for autism. However, some studies suggest that stem cells may help in certain aspects. Some patients improve in communication and behavior. It is not a magic solution, but there are positive cases. The results depend on the individual.
2. How long does it take to notice improvements?
Each patient evolves at his or her own pace. Some parents notice changes in a few months, such as better social interaction or increased concentration. Others see slower progress. The important thing is to have realistic expectations and to follow up with specialists.
3. Is the treatment safe?
If performed in specialized centers with trained physicians, the studies consider it safe. Not all clinics meet the standards. It is essential to investigate before deciding.
4. How much does the treatment cost in Turkey?
The price varies according to the clinic, the type of cell therapy for autism and the sessions needed. Turkey offers quality at more affordable prices.
5. How to access treatment with VisitandMedCare?
You can contact VisitandMedCare through their website or social networks. Their team will guide you through the whole process.
Conclusion
Stem cell treatment in Turkey may improve certain aspects of autism. Be well informed and choose a reputable site. VisitandMedCare can help you. WhatsApp or call us at +90 552 935 2370 and get in touch with an expert at our autism stem cell clinic in Istanbul. Is this option worth exploring for your loved one?






